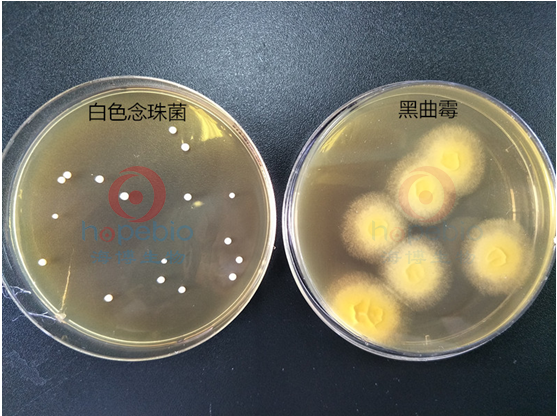

海博微信公众号
海博微信公众号
 海博天猫旗舰店
海博天猫旗舰店


 海博微信公众号
海博微信公众号
 海博天猫旗舰店
海博天猫旗舰店




一、目的和用途
该培养基用于真菌的检测。具体用于医药工业洁净区沉降菌和浮游菌中真菌的测定(GB),也用于药品白色念珠菌的培养,霉菌及酵母菌计数等(药典)。
二、培养基成分
|
动物组织胃蛋白酶水解物和胰酪胨等量混合物 |
10.0g |
|
葡萄糖 |
40.0g |
|
琼脂 |
15.0g |
|
水 |
1000ml |
|
pH |
5.6±0.2(25℃) |
三、试验原理
动物组织胃蛋白酶水解物和胰酪胨等量混合物提供氮源等营养;葡萄糖提供碳源;琼脂是培养基的凝固剂。
四、使用方法
1. 称取沙氏葡萄糖琼脂培养基65g,加入蒸馏水或去离子水1 L,搅拌加热煮沸至完全溶解,分装三角瓶,121℃灭菌15分钟。
2. 取待检菌的新鲜培养物划线接种于平板上,于20-25℃培养48~72h,观察结果。
五、质量控制及结果判定
1. 外观方面
干粉培养基:淡黄色粉末。
2.生物学方面
接种以下质控菌株,放置20-25℃需氧培养48~72小时。结果如下(表格和图片):

六、注意事项
由于霉菌会产生大量孢子,并且容易散落在空气中,对实验室环境造成污染,而很难消灭干净,给实验人员造成很大困扰。因此检测之后的培养物必须严格控制,及时置于121℃下高压灭菌1小时后丢弃。
相关产品:
沙氏葡萄糖琼脂培养基(SDA)(中国药典)-点击查看产品详情
上一篇:BCYE培养基原理及实验现象



